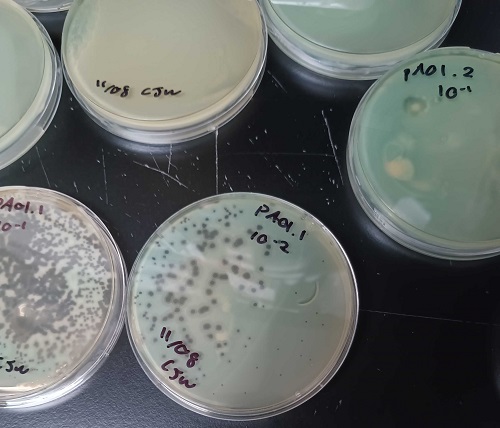
630faa675d88407c8f1b51eb4061c9d2.jpg 630faa675d88407c8f1b51eb4061c9d2.jpg

【生命科普】工程病毒诱使致命病原体自我毁灭,有望治疗抗生素耐药性感染
来源: 科技日报
作者: 张佳欣
培养皿中的黑点标志着噬菌体从细菌中爆发出来并杀死细菌的区域。图片来源:科尔·威尔逊/西北大学
科技日报记者 张佳欣
据近日发表在《微生物学光谱》杂志上的论文,美国西北大学的研究人员成功诱使一种致命的病原体从内到外自我毁灭。该项研究标志着治疗抗生素耐药性感染迈出关键一步。
日益严重的抗生素耐药性危机促使研究人员寻找抗生素的替代品。为了探索潜在的噬菌体疗法,研究人员要么精确定位现有病毒,要么修改现有病毒,以选择性地针对细菌感染,而不损害身体的其他部分。
此次,研究人员决定将重点放在铜绿假单胞菌上,这是人类5种最致命的病原体之一。研究人员从铜绿假单胞菌的几种噬菌体中提纯了DNA。然后,他们使用电穿孔技术在细菌的外层细胞上戳出临时的洞。通过这些洞,噬菌体DNA进入细菌以模拟感染过程。
在某些情况下,细菌会将DNA识别为异物,并将其粉碎以保护自己。但在使用合成生物学优化该过程后,研究人员能够消除细菌的抗病毒自卫机制。于是,DNA成功地将信息带入细胞,产生杀死细菌的病毒粒子。整个过程中,数十亿个噬菌体从细菌中暴发出来,并杀死了细菌。
接下来,研究人员计划修改噬菌体DNA,以优化潜在的治疗方法。理想情况下,科学家有朝一日可量身定做一种噬菌体,并设计出具有精确特征的“点菜”疗法来治疗个别感染。

 豫公网安备 41040302000058号
豫公网安备 41040302000058号
